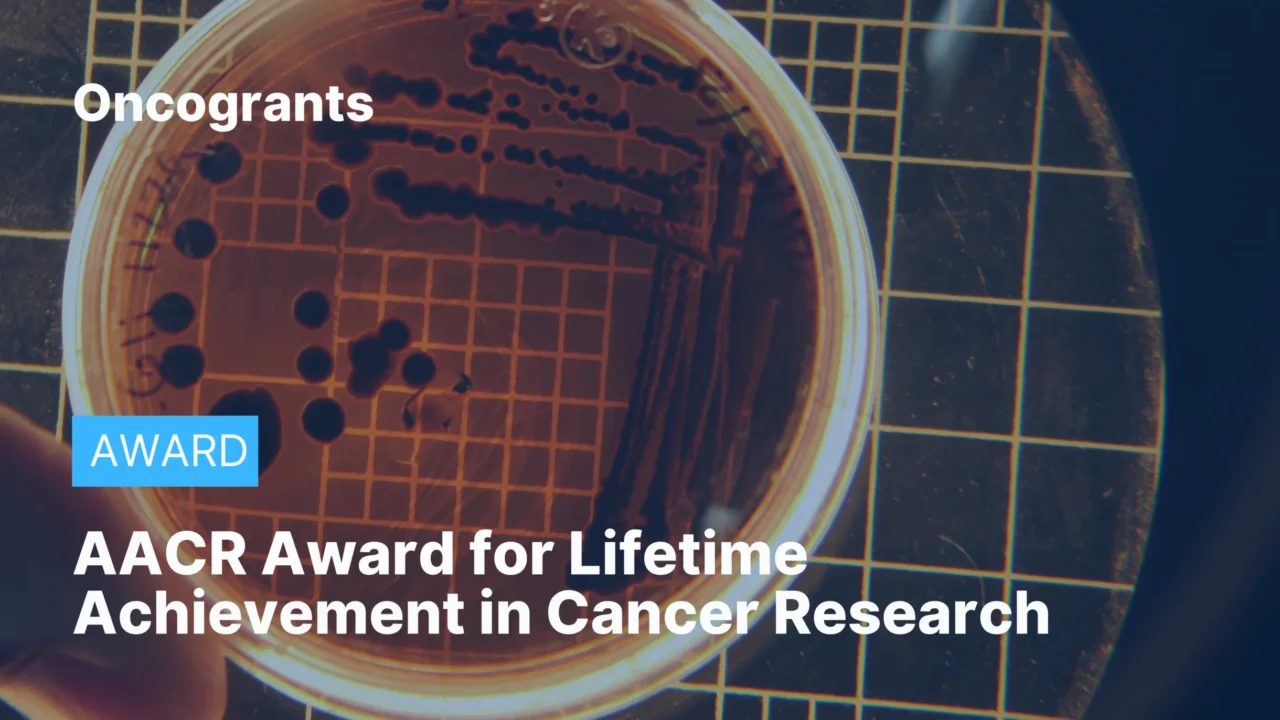
AACR Award for Lifetime Achievement in Cancer Research

This AACR award honors an individual with significant fundamental contributions to cancer research—through a single major discovery or a body of work—with lasting impact on the field, including research, leadership, and/or mentorship.
Eligibility Criteria:
- Cancer researchers worldwide (academia, industry, government) may be nominated (current or previous affiliation).
- Individual investigators only (institutions/organizations are not eligible).
- Recipient is expected to be present to receive the award unless unable due to health restrictions or other serious conflicts.
Funding Details:
- Recognition award within AACR’s Scientific Achievement Awards program.
- Nominations submitted via AACR’s electronic nomination platform; self‑nominations prohibited.
Deadline:
- June 30, 2026 (nominations open January 1, 2026)
Where to go for further information: